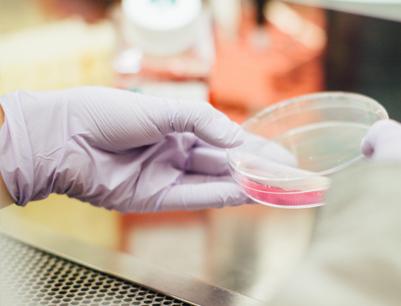

Copyright 2019 北京阅微基因技术股份有限公司京ICP备09053524号

儿童用药安全的“精准武器”
目前国内儿童药物制剂仅占全部市场的1.7%,临床上普遍存在给儿童减量使用成人处方药的现象。但实际上,儿童对药物的敏感性和耐受性…

药物基因检测如何切合临床实践?试试CPIC指南吧!
临床给药走向精准化,采用个体化给药剂量才能最大程度地避免严重的毒副作用。但如何确保检测“切实有用”,如何杜绝过度检测与无临…

真实世界的替格瑞洛是否能够完全替代氯吡格雷?
随着科技的进步,出现了氯吡格雷抗血小板药物个体化用药方案和新型抗凝药,如替格瑞洛、普拉格雷等,其中阿斯利康的替格瑞洛和信立…

什么?葡萄胎也是一种肿瘤?
李女士与丈夫结婚3年终于查出来怀孕2个多月,全家人很高兴,但近几天李女士发现阴道有不规则出血,并伴有下腹阵发性疼痛,怀疑要流…

预防“唐宝宝”,每位准爸妈都应该知道这些事
产检对于每位孕妈来说都是既期盼又忐忑。新手准妈妈小红初次怀孕,产检唐筛结果显示“21三体高风险”,需要进一步确诊,医生推荐做…

寒冬腊月,不输液的我靠啥”通血管”?
“有病治病,没病预防,输液通血管。“是错的!

你是准备好做父母了,但你问过基因的意见了吗?
合适的伴侣不仅仅要彼此欣赏,基因上的“门当户对”对下一代也是万分关键的,因为基因上的优良结合,可以扬长避短,降低出生缺陷,…
为什么推荐子宫内膜癌患者进行MSI检测
MSI(微卫星不稳定)作为FDA批准的首个泛癌种免疫检查点抑制剂疗效预测分子标记物,临床上最广泛的应用是辅助结直肠癌患者选择治疗手…


